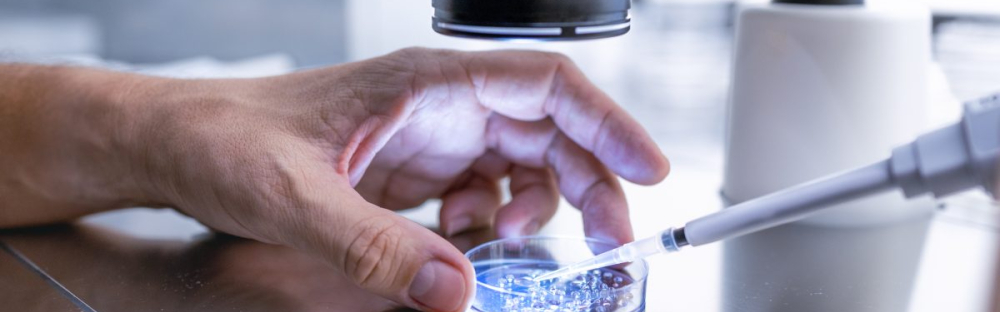
8a6c0c7061ad-GettyImages-1498980269-2-1200x800.jpg

Insights más recientes
Insights
Insights más recientes
Barómetro C-suite: perspectiva del sector manufacturero

En un contexto global marcado por la incertidumbre y la transformación acelerada del panorama industrial, los líderes del sector manufacturero enfrentan una presión creciente para adaptarse y mantenerse competitivos. A pesar de ello, muchos continúan confiando en sus ambiciones de crecimiento. En este escenario cambiante, la agilidad estratégica se ha convertido en un activo indispensable. Basado en las opiniones de ejecutivos de más de 35 países, nuestro reporte analiza cómo las empresas del sector están respondiendo al cambio y dónde están encontrando nuevas oportunidades para impulsar su desarrollo.
Barómetro C-suite: perspectivas del sector de ciencias de la vida y farmacéutica
5 de agosto de 2025
En un año marcado por la incertidumbre a nivel global, los cambios regulatorios y una innovación acelerada, los líderes del sector de ciencias de la vida y farmacéutica están redefiniendo sus prioridades estratégicas. Basado en las opiniones de ejecutivos de más de 35 países, nuestro reporte más reciente muestra cómo las empresas del sector están enfrentando la complejidad, invirtiendo en el crecimiento y posicionándose para lograr el éxito a largo plazo en un entorno competitivo.
Reporte global de capital privado 2025

Puede que el mercado internacional sea volátil, pero las perspectivas del sector de capital privado muestran una confianza creciente. En este reporte, descubrimos por qué las empresas de capital privado siguen siendo optimistas de cara a 2025 y qué estrategias están empleando para impulsar la inversión.
No es si pasará, sino cuándo. Reforzar la red de seguridad para mejorar la resiliencia cibernética

Las amenazas cibernéticas nos rodean. No se trata de paranoia, sino de una desafortunada realidad: cada día se producen nuevos hackeos, nuevas filtraciones de datos, trampas y nuevos gastos, tanto financieros como comerciales. Nadie se salva. Los ataques se dirigen a empresas grandes y pequeñas, así como a instituciones públicas y particulares. ¿Cómo pueden protegerse las organizaciones?
El nuevo panorama de los ciber riesgos

El uso de la mayoría de las empresas de la tecnología y los datos es innegable. Sin embargo, a medida que esta dependencia aumenta, también lo hacen los riesgos en torno a la ciberseguridad.
Una guía práctica sobre sostenibilidad para consejos de administración y equipos directivos

15/11/2021 Dado a que las expectativas de la sociedad están cada vez más presentes en el gobierno corporativo, las empresas deben evolucionar sus modelos de negocio para adoptar una creación de valor duradero que beneficie no solo a los accionistas, sino también a los grupos de interés internos y externos, así cómo a la sociedad en general.
The race to data maturity
Businesses understand they need to leverage data to stay competitive and unlock future growth. All over the world,
they’re devoting significant executive time and betting big on new technologies to gain a competitive advantage. But do they have the data maturity to reach their objectives?
they’re devoting significant executive time and betting big on new technologies to gain a competitive advantage. But do they have the data maturity to reach their objectives?
Desbloquear la confianza: por qué el cumplimiento global está en en la lista de prioridades de las empresas

El cumplimiento ha sido durante mucho tiempo una pieza clave de las buenas prácticas empresariales. Sin embargo, todavía puede considerarse como una obligación que hay que cumplir, en lugar de un generador de valor. Por este motivo, hemos realizado una encuesta sobre la forma en que los líderes empresariales abordan el cumplimiento global, incluyendo dónde centran la inversión, los riesgos que anticipan y lo que esperan del "buen cumplimiento".
Carve-outs en la industria automotriz

La industria automotriz está en constante cambio, enfrentando desafíos externos que se plantean en torno a las nuevas tecnologías y modelos de negocios. Los carve-outs son el centro de atención para ayudar a las empresas a mitigar esos riesgos y ofrecer oportunidades estratégicas. Los expertos de Mazars alrededor del mundo ofrecen información acerca de los carve-outs, desde una variedad de perspectivas estratégicas distintas.
El futuro de la auditoría: visión del mercado - mitos, realidades y formas de avanzar

12/02/21 La profesión de la auditoría se enfrenta a un momento decisivo: las expectativas del mercado están cambiando, la tecnología está fortaleciendo a los auditores y robusteciendo la calidad, los motivos para que la auditoría evolucione son cada vez mayores y una serie de importantes fracasos corporativos han planteado dudas sobre la calidad del servicio que las empresas pueden esperar.
Consciente, colaborativo, conectado: la renovación del modelo de negocios de la industria del lujo

El sector del lujo siempre se ha enorgullecido de ofrecer a los consumidores la posibilidad de poseer piezas que son atemporales y cuyo valor y atractivo perdurarán. Pero eso no significa que la forma en que las produce y vende deba seguir siendo la misma. El sector del lujo está en una encrucijada y las marcas que siguen haciendo lo que siempre han hecho corren el riesgo de quedarse atrás, nuestro reporte “Consciente, colaborativo, conectado” explica las razones.
Reinventando la rueda: lo que está impulsando el cambio en la movilidad del siglo XXI

¿Cómo puede el sector de la movilidad responder a la evolución de las expectativas de los consumidores para influir y liderar una transformación hacia sistemas más limpios, conectados y colaborativos?
Smarter, better, faster: RPA en acción

Como resultado de la pandemia de Covid-19, todos los sectores están bajo presión para ganar eficiencia, aumentar la innovación y encontrar nuevas formas de trabajo. La Automatización Robótica de Procesos (RPA por sus siglas en inglés) está en el centro de la acción para ayudar a las empresas a lograr precisamente eso. En Smarter, Better, Faster: RPA en acción, nuestros expertos analizan siete sectores clave afectados por la pandemia para ofrecer ejemplos reales de cómo se puede utilizar RPA en cada sector, los beneficios de su implementación y cómo adoptarlo correctamente.